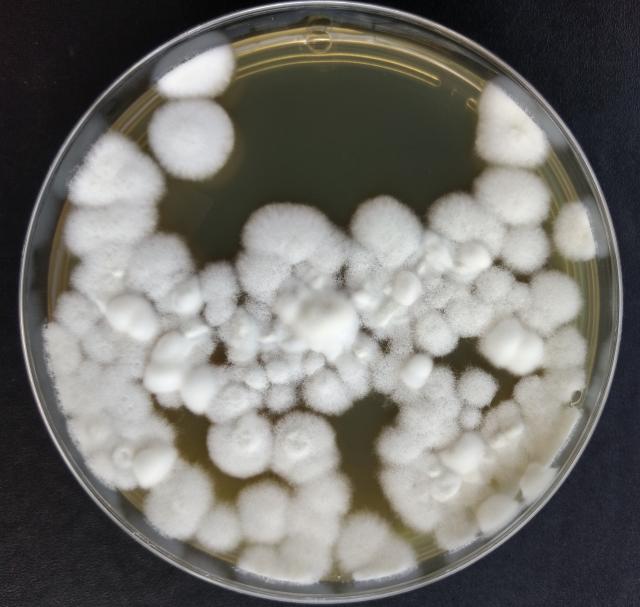

Cientistas brasileiros e americanos conduziram uma pesquisa que pode revolucionar o controle de pragas nas lavouras. O estudo, que utilizou a tecnologia de edição genética CRISPR-Cas9, mostrou que o fungo Beauveria bassiana, conhecido por suas propriedades entomopatogênicas, pode se tornar ainda mais eficaz na eliminação de insetos. A chave para essa melhoria está na alteração de um gene específico, o Bbsmr1, que potencializa a ação do fungo, tornando-o uma opção mais potente e sustentável como bioinseticida.
De acordo com Gabriel Mascarin, analista da Embrapa Meio Ambiente (SP), a versão inicial do fungo é geneticamente modificada, o que a classifica como transgênica, devido à inserção de um gene de resistência. Contudo, em futuras fases da pesquisa, a intenção é aplicar a edição genética sem a introdução de DNA de outras espécies. Dessa forma, os fungos modificados seriam classificados como convencionais e poderiam ser liberados no mercado de bioinseticidas no Brasil com mais facilidade.
O estudo comparou duas formas do fungo: os blastosporos, células semelhantes a leveduras, e os conídios, a forma mais utilizada nos micopesticidas comerciais. Os resultados foram surpreendentes. Os blastosporos mostraram-se 3,3 vezes mais letais e 22% mais rápidos em eliminar insetos, atingindo 97% de mortalidade nas larvas da traça-da-cera em apenas cinco dias, enquanto os conídios chegaram a 29,4%. Além disso, a produção de blastosporos é mais eficiente, sendo realizada em apenas dois a três dias, comparado aos mais de dez dias necessários para os conídios.
A edição genética do gene Bbsmr1, foco da pesquisa, revelou ainda mais vantagens. Os fungos modificados apresentaram uma mortalidade de 50% nos insetos em apenas três dias, mesmo com doses menores. Eles também mostraram uma germinação mais rápida na cutícula e maior proliferação de blastosporos no corpo dos insetos, aumentando sua eficácia. Outra descoberta importante foi a produção excessiva de oosporina, uma substância que enfraquece o sistema imunológico do inseto, acelerando sua morte.
Além de auxiliar no controle de pragas, a oosporina também demonstrou propriedades antifúngicas e antibacterianas, com potencial para atuar como biofungicida contra patógenos de plantas, como o Fusarium oxysporum, causador de doenças em tomateiros e bananeiras.
A tecnologia CRISPR-Cas9, utilizada nesta pesquisa, é conhecida por sua precisão. Testes genômicos confirmaram que as modificações não causaram mutações fora do alvo, garantindo a segurança da técnica. Com esses avanços, fungos modificados sem a inserção de DNA de outras espécies poderão ser liberados com mais rapidez pelos órgãos reguladores, oferecendo uma solução mais ágil e eficaz para o controle biológico de pragas agrícolas.